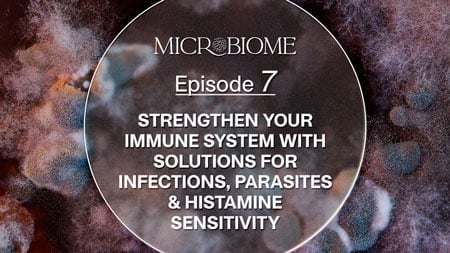

Support Our Mission & Own The Entire Series Now
BONUSES AND DISCOUNTS FOR ALL SUPPORTERS, LIMITED TIME ONLY
BONUS OFFER FOR A LIMITED TIME!
PLATINUM DIGITAL
ONLINE ACCESS

$2702
$197
- 10 Episodes Videos (Online Access)
- 10 Episode Transcripts (PDF Download)
- 10 Episode Audios (MP3 Downloads)
- BRAND NEW BONUS: Our 4-week Implementation Guide (PDF Download)
($147 value - YOURS FREE!)
- BONUS: Full-Length Interviews + Transcripts (Online Access & PDF Download)
($197 value - YOURS FREE!)
- BONUS: Expert Q&A Sessions Library with Over 50+ Videos! (Online Access)
($147 value - YOURS FREE!)
- BONUS: Episode Summaries and Protocols (PDF Download)
($297 value - YOURS FREE!)
- BONUS: Quick-Start Gut Breakthrough Guides (PDF Download)
($197 value - YOURS FREE!)
- BONUS: The Good Gut Kitchen with Dr. Ritamarie (Recipes + Cooking Demonstrations) (Online Access & PDF Download)
($197 value - YOURS FREE!)
- BONUS: The Microbiome Makeover: Gut-Healing Recipes & Tutorials with Chef Camila Skaf (Online Access & PDF Download)
($197 value - YOURS FREE!)
- BONUS: 28-Day Gut Restore Meal Plan + Shopping Lists (PDF Download)
($247 value - YOURS FREE!)
- BONUS: The Step-By-Step Guide to Total Body Detoxification (PDF Download)
($197 value - YOURS FREE!)
- BONUS: The Goodness Lover Wellness Journal (PDF Download)
($47 value - YOURS FREE!)
- BONUS: The Goodness Lover Inner Circle Community (Online Access)
($497 value - YOURS FREE!)
- BONUS: Certificate of Completion (PDF Download)
($57 value - YOURS FREE!)
- BONUS: Expert Directory (PDF Download)
($14 value - YOURS FREE!)

(Price Quoted in USD)
BONUS OFFER FOR A LIMITED TIME!
Best Value!
PLATINUM PREMIUM
DIGITAL & SHIPPED PRODUCT

$3300.85

$279
- 10 Episodes Videos (DVDs & Online Access)
- 10 Episode Transcripts (Bound Book & PDF Download)
- 10 Episode MP3 Audios (MP3 Downloads)
- BONUS: Gut Restore Supplement Package (Shipped)
($154.85 value - YOURS FREE!) Includes:

-
Better Gut Prebiotic Fiber Plus (
$59.95Value, Yours FREE!) -
Digest & Debloat Pro (
$49.95Value, Yours FREE!) -
L-Glutamine Powder (
$44.95Value, Yours FREE!)
- BRAND NEW BONUS: Our 4-week Implementation Guide (PDF Download)
($147 value - YOURS FREE!)
- BONUS: Full-Length Interviews + Transcripts (Online Access & PDF Download)
($197 value - YOURS FREE!)
- BONUS: Expert Q&A Sessions Library with Over 50+ Videos! (Online Access)
($147 value - YOURS FREE!)
- BONUS: Episode Summaries and Protocols (PDF Download)
($297 value - YOURS FREE!)
- BONUS: Quick-Start Gut Breakthrough Guides (PDF Download)
($197 value - YOURS FREE!)
- BONUS: The Good Gut Kitchen with Dr. Ritamarie (Recipes + Cooking Demonstrations) (Online Access & PDF Download)
($197 value - YOURS FREE!)
- BONUS: The Microbiome Makeover: Gut-Healing Recipes & Tutorials with Chef Camila Skaf (Online Access & PDF Download)
($197 value - YOURS FREE!)
- BONUS: 28-Day Gut Restore Meal Plan + Shopping Lists (PDF Download)
($247 value - YOURS FREE!)
- BONUS: The Step-By-Step Guide to Total Body Detoxification (PDF Download)
($197 value - YOURS FREE!)
- BONUS: The Goodness Lover Wellness Journal (PDF Download)
($47 value - YOURS FREE!)
- BONUS: The Goodness Lover Inner Circle Community (Online Access)
($497 value - YOURS FREE!)
- BONUS: Certificate of Completion (PDF Download)
($57 value - YOURS FREE!)
- BONUS: Expert Directory (PDF Download)
($14 value - YOURS FREE!)

(Price Quoted in USD)
*All digital products are available instantly after purchase. Your physical items will ship within 5-10 business days.
BONUS OFFER FOR A LIMITED TIME!
PLATINUM PHYSICAL
SHIPPED PRODUCT

$2999
$279
- 10 Episodes Videos (DVDs)
- 10 Episode Transcripts (Bound Book)
- 10 Episode MP3 Audios
- BRAND NEW BONUS: Our 4-week Implementation Guide (PDF Download)
($147 value - YOURS FREE!)
- BONUS: Full-Length Interviews + Transcripts (Online Access & PDF Download)
($197 value - YOURS FREE!)
- BONUS: Expert Q&A Sessions Library with Over 50+ Videos! (Online Access)
($147 value - YOURS FREE!)
- BONUS: Episode Summaries and Protocols (PDF Download)
($297 value - YOURS FREE!)
- BONUS: Quick-Start Gut Breakthrough Guides (PDF Download)
($197 value - YOURS FREE!)
- BONUS: The Good Gut Kitchen with Dr. Ritamarie (Recipes + Cooking Demonstrations) (Online Access & PDF Download)
($197 value - YOURS FREE!)
- BONUS: The Microbiome Makeover: Gut-Healing Recipes & Tutorials with Chef Camila Skaf (Online Access & PDF Download)
($197 value - YOURS FREE!)
- BONUS: 28-Day Gut Restore Meal Plan + Shopping Lists (PDF Download)
($247 value - YOURS FREE!)
- BONUS: The Step-By-Step Guide to Total Body Detoxification (PDF Download)
($197 value - YOURS FREE!)
- BONUS: The Goodness Lover Wellness Journal (PDF Download)
($47 value - YOURS FREE!)
- BONUS: The Goodness Lover Inner Circle Community (Online Access)
($497 value - YOURS FREE!)
- BONUS: Certificate of Completion (PDF Download)
($57 value - YOURS FREE!)
- BONUS: Expert Directory (PDF Download)
($14 value - YOURS FREE!)

(Price Quoted in USD)
*All digital products are available instantly after purchase. Your physical items will ship within 5-10 business days.
PLATINUM PREMIUM ONLY
BONUS #1
Gut Restore Supplement Package
3 powerful supplements to fast track healing your gut & support digestive health


($59.95 value - YOURS FREE!)
Better Gut Prebiotic Fiber Plus: Nourish Your Gut With One Teaspoon A Day
If you only take one supplement for gut health, make it Better Gut Prebiotic Fiber Plus.
Prebiotics are food for the microbes that support good health. Better Gut Prebiotic Fiber Plus nourishes the microbiome for improved gut health, lower inflammation, and enhanced immune status.
By shifting the composition of the microbiome with Better Gut Prebiotic Fiber Plus, you can enhance the health of your digestive tract and beyond.

($49.95 value - YOURS FREE!)
Digest & Debloat Pro: The Most Advanced Formula For Total Digestive Relief
With plant-based digestive enzymes, a potent probiotic, and targeted botanical extracts, this comprehensive supplement tackles digestive issues at their root.
Our powerful 7-enzyme blend acts like tiny keys breaking down your food the right way, stopping bloat before it starts. The added benefit? Your energy will soar now that your body is absorbing all the nutrients it needs.
Next, our botanicals, fennel, lemon balm, GutGard®, work to calm and soothe irritated digestive tissues, providing much-needed relief from discomfort and bloating. Think of it like a spa day for your tummy.
Finally, the probiotic strain lactobacillus rhamnosus GG reinforces your gut’s “good” bacteria, promoting a healthy, balanced microbiome that’s essential for smooth digestion and long-term gut health.

($44.95 value - YOURS FREE!)
The Ultimate Multi-Tasker: L-Glutamine Powder
One of the most important nutrients for gut repair, L-glutamine can relieve the gas, bloating, and pain caused by leaky gut. It also may prevent serious complications caused by poor gut health.
At times of stress, injury and illness, the body cannot produce enough L-glutamine to meet its demands. Supplemental L-glutamine buffers the impacts of stress and may protect the body from inflammation, autoimmune disorders, and chronic disease. L-glutamine supports the repair of leaky gut and enhances immune function.
Value: $154.85
Your Price: FREE with Platinum Premium
Your Platinum Package Includes
All 10 Episodes of Microbiome
Online Access & on DVD


Episode 1
The Microbiome Solution: Discover Where Better Health Begins
- The subtle symptoms of gut imbalances (and how small irritations can snowball into big problems)
- What causes problems in the microbiome - and the everyday steps you can take to prevent them
- The #1 most important nutrient for maintaining health and preventing disease (and what it means for the 95% of us who aren’t getting enough)
- The best supplement to support the gut - especially for people who can’t tolerate a broad diversity of plant foods

Episode 2
The Autoimmune Solution: Overcome Leaky Gut & Food Sensitivities
- The relationship between leaky gut and the development of autoimmune diseases
- What causes a leaky gut in the first place? Find out if there’s a part of your lifestyle that’s unknowingly damaging your gut
- All-natural ways to heal your gut lining — from the right foods to eat to easy lifestyle changes to the right supplements and herbs
- The doctor-approved protocols to overcome food sensitivities, especially if you cannot tolerate some healthy foods like broccoli or beans

Episode 3
Conquer Constipation, Reflux & IBS with Probiotics & Fermented Foods
- The secrets behind gut motility and bowel movements (things we need to discuss, but often are embarrassed to ask)
- What your poop is trying to tell you (and find out what your bowel movements reveal about your health status)
- The 5 steps to picking the right probiotic according to a microbiome research expert
- The constipation relief technique the internet can’t stop talking about (and learn how to perform the viral “internal shower”)
- The best fermented foods you can eat today to boost beneficial gut bacteria

Episode 4
Unlock the Power of the Vagus Nerve to Beat Anxiety, Depression & Stress
- What exactly is the gut-brain connection (+plus natural remedies for anxiety, depression, and stress)
- The link between brain disorders and bad gut bacteria (like dementia, cognitive function, Alzheimer's, and Parkinson's)
- How to unlock the power of your vagus nerve for better mental health
- An emerging new treatment that introduces good bacteria into your gut—fast
- How a popular and easily prescribed anti-inflammatory medication can wreak havoc on your gut (plus holistic alternatives that work just as well without hurting your gut)

Episode 5
Say Goodbye to Gas & Bloating with Natural Solutions for SIBO & Candida
- Why we need to take bloating seriously (and how you can put an end to this painful and embarrassing symptom)
- The ancient Ayurvedic remedy for constipation and bloating that is still used to this day (and learn how to use it to improve your digestion)
- The herbal treatments for bacterial overgrowth that are proven to be just as effective as antibiotics
- How to recognise the subtle signs of excess Candida (+plus discover potent herbal remedies for fungal overgrowths)

Episode 6
How to Detox Your Gut & Reclaim Your Health
- The role your gut plays in keeping your body’s detoxification process running
- How to recognise the symptoms of toxin exposure that often get confused with other conditions
- A stealth pathogen in your home that could be silently affecting the brain and nervous system without you knowing
- A unique probiotic that prevents harmful metals like lead, arsenic, and cadmium from getting into your cells
- The critical first step to detoxification that most people miss
Episode 7
Strengthen Your Immune System with Solutions for Infections, Parasites & Histamine Sensitivity
- The real reason some infections never seem to go away (+plus discover the key to restoring your immune system and getting your energy back)
- How a parasite could be draining your energy – even if you think you haven’t been exposed – and discover the herbal treatments that actually work
- Biofilms – the “communities” of bacteria and viruses that make themselves at home in your body – and how they disrupt your health (did you know they can “vote”?)
- Learn about herbal remedies for quelling histamine flare ups and the #1 thing most people do wrong when it comes to natural treatments for histamine intolerance

Episode 8
Microbiome Mastery & The Longevity Diet
- How people who stay healthy into their 90s (and beyond!) supercharge their microbiome to prolong their years of health and happiness
- The best—and worst—foods for your gut (including a popular diet that wreaks havoc on the microbiome)
- The one thing that can restore your microbiome in just 3 days (according to researchers at Harvard University)
- How to elevate common foods to superfood status with simple (and time-saving!) meal prep magic
- The foods that help you lose more weight the more you eat (and they’re good for your gut, too!)

BONUS Episode 9
Beat Sleep Challenges & Boost Your Energy
- The sleep-inducing flower that Benedictine monks used in the middle ages to get better sleep
- How your sleep schedule impacts your microbiome (and find out what bedtime your microbiome prefers!)
- How to harness the power of the sun to have more energy, better focus, and a healthier gut
- Potent, yet gentle herbal remedies that safely help you fall and stay asleep

BONUS Episode 10
Microbiome Skin Care: Revealing The Gut-Skin Solution
- The probiotic that reduces acne by 70%
- How to tell if your acne, eczema, or rosacea is actually a symptom of a gut problem (+plus learn how to naturally soothe and restore your skin)
- Why you might want to think twice about taking antibiotics for skin issues
- How viruses (yes, you read that right!) might be the best alternative to antibiotics
You'll Also Receive:

Audio Recordings
CD + Downloadable MP3s
What would your life be like if you could listen and learn on the go?
Many people retain information better by hearing it aloud. And that’s why we’re giving you every single second of the series as an audio download.
Whether you’re commuting, cooking, taking your morning walk, traveling, hitting the gym, or winding down at night – listen to the audio format of the content whenever and wherever you like.
Having these audio tracks means you can live your life – and restore your gut – on your own terms.

Transcripts
Printed Book + Downloadable PDF
Do you learn better by reading?
65% of the population are visual learners. That’s why we’re giving you full transcripts of all 10 sessions.
Reading is proven to reinforce information and what’s inside this program can be quite scientific. These transcripts offer a multi-format learning experience which has been shown to lead to the greatest comprehension of new information.
Read at your own pace to gain a deeper understanding and ground important concepts. The more you understand about your gut, the more you’ll be able to share this amazing knowledge with your loved ones!
27 World-Renowned Experts, Researchers and Doctors Have Come Together to Help Transform Your Health
To help people like you, we pooled the collective wisdom and experience of 27+ world-class experts. We’ve distilled their knowledge into a streamlined masterclass series to bring your body back into health and well-being.

Dr. Catherine Clinton
Naturopathic Physician, Researcher, Author

Dr. Christina Miller
Emergency & Integrative Medicine Doctor

Dr. Cyrus Khambatta
Nutritionist, Bestselling Author

Dr. Daryl Gioffre
Chiropractic Physician, Bestselling Author

Dr. David Perlmutter
Neurologist, 6x NYT Bestselling Author

Dr. Elena Ivanina
Gastroenterologist, MPH

Dr. Felice Gersh
OB-GYN & Integrative Medical Doctor

Dr. Fred Harvey
Internal Medicine Physician, Holistic Physician

Dr. Gerry Curatola
Dentist, Associate Professor, Author

Dr. Hana Kahleova
Endocrinologist, Researcher, Author

Dr. Ilana Gurevich
Naturopathic Physician

Dr. Jason Hawrelak
Naturopathic Physician, Researcher

Dr. Joel Fuhrman
Family Physician, 7x NYT Bestselling Author

Kiran Krishnan
Research Microbiologist

Dr. Liz Lipski
Professor, Clinical Nutritionist

Dr. Mary Pardee
Naturopathic Physician, Functional Medicine Doctor

Dr. Maura Henninger
Naturopathic Physician, Board Certified Nutrition Specialist

Dr. Nirala Jacobi
Naturopathic Doctor

Ocean Robbins
Health Researcher, Author

Dr. Peter Bongiorno
Naturopathic Doctor, Medical Textbook Author

Dr. Peter Kan
Board-Certified Chriropractic Neurologist

Dr. Ritamarie Loscalzo
Chiropractic & Nutritional Endocrinology Doctor,Author

Dr. Sarina Pasricha
Internal Medicine Physician, Gastroenterologist

Dr. Vincent Esposito
Doctor of Chiropractic, Nutritionist

Dr. Wendy Romig
Doctor of Clinical Nutrition, Clinical Herbalist

Dr. Will Bulsiewicz
Internist, Gastroenterologist, NYT Bestselling Author

Dr. Will Cole
Doctor of Chiropractic, Doctor of Natural Medicine, Author
PLUS Receive Over $2,500+ in Must-Have Bonuses
All The Tools You Need To Nourish Your Microbiome And Restore Your Gut Health
BRAND NEW BONUS
Our 4-week Implementation Guide
Our experts' knowledge–in simple, powerful, and doable steps

Knowing how to repair your gut and restore the community of microbes living within is one thing, but translating that knowledge into actionable steps for real-life application is another challenge altogether.
If you’re wrestling with the silent struggle of gut issues and are feeling overwhelmed on how to get your gut health back on track, this 4-Week Implementation Guide is for you.
Guiding you through the four pivotal areas essential for a gut health transformation – steering clear of gut disruptors, optimizing nutrition, embracing healthy lifestyle habits, and integrating targeted supplementation – this guide empowers you to take control of your gut health with confidence.
Value: $147
Your Price: FREE
BONUS #3
Full-Length Interviews
Watch all the uncut interviews (Plus transcripts!)

Imagine having the opportunity to have the leading experts in gut health, detox, food sensitivities, vagus nerve, and nutritional wellbeing come to your home and teach you the latest strategies for optimizing your health…
Well, now you can! Watch each and every full-length interview that went into the making of the Microbiome masterclass.
You’ll learn about all of the important topics that we just couldn’t fit into one masterclass and get to hear each expert’s complete ideas on the topics they are most passionate about.
When you choose the Platinum Premium Package, you get more than 30 hours of unedited advice from the top experts in the field.
Value: $197
Your Price: FREE
BONUS #4
Expert Q&A Session Library (50+ Videos!)
Our doctors address the most common health concerns of people just like you

Our doctors address the most common health concerns of people just like you. Go behind closed doors in our doctors’ office – watch recorded Q&A sessions in this hand-curated library of videos.
See how doctors respond to people just like you!
You’ll be surprised how many people are struggling with the same things as you… whether it be from a leaky gut, toxin buildup, food sensitivities, gas, bloating, anxiety, depression…
Or more acute challenges like arthritis, cardiovascular disease, gastrointestinal issues, cancer, diabetes, kidney disease, fatty liver disease, autoimmune, or neurodegenerative conditions… our incredible doctors tackle these issues and much more in our recorded Q&As.
Value: $147
Your Price: FREE
“Thank you so much for creating Microbiome. It is so beautifully put together! The content is so informative and fascinating, and the materials are just beautifully organized – all so clear! I love all different aspects of it – the main episodes, having the full-length interviews both audio and transcript form – and the summaries are amazing! I’ve bought many programs over the years – especially recently – and I don’t think I’ve ever come across one quite like this… Thank you so much for all the work you have put into creating this program. I am so grateful to have purchased it! Blessings to all of you who have created this extraordinary program.”
- Patience B. Verified Customer
BONUS #5
Episode Summaries & Protocols
Recap the main points of each episode PLUS corresponding protocols

When you choose to own the series today, you’ll be totally taken care of with our step-by-step support! You’ll receive 10 PDFs that neatly summarize the main points of each episode.
We also included the protocols that you can follow weekly or at your own pace—whichever you feel comfortable to do!
Each of the 10 protocols has been carefully crafted to help you create your own personalized gut-restoring blueprint, so you can feel safe, secure, and supported on your journey to healing.
You’ll learn what action steps to take and when, what to eat, what to avoid, the right way to detox your body, which natural remedies actually work, how to stimulate your vagus nerve, and how to sleep better… plus so much more!
This takes the guesswork out of knowing how to implement your new knowledge into your daily life – and saves you time and headache trying to figure which step to take next.
We know there’s a lot of confusion and misinformation out there about how to manage your health effectively. And we’d never give you all this information and then leave you to figure it all out on your own. Your life is full enough already!
Instead, you’ll be guided through each episode, one step at a time, all from the comfort of your own home. You can follow every week or take it as slow as you’re comfortable doing – it’s totally up to you!
Value: $297
Your Price: FREE
BONUS #6
Quick-Start Gut Breakthrough Guides
Pick the gut protocol that you need to start with

There’s no one-size-fits-all approach to healing your gut.
Some might need to start with an elimination diet, while some might need help with gas and bloating. You might need to start with some vagus nerve exercises for your mental health, or you might need supplements like prebiotics or digestive enzymes.
Whichever approach you need right now, our Quick-Start Gut Breakthrough Guides are here to help!
Included in this bundle are 24 different strategies all targeted to repair your gut. No more googling for hours. No more reading tons of research with confusing jargon. The protocols are laid out on each PDF for you. All you need to do is pick those that you need!
- How to Do an Elimination Diet
- The A to Z of Leaky Gut Remedies
- 8 Fun and Effective Exercises to Stimulate Your Vagus Nerve
- The Essential Guide to Purchasing and Taking Probiotic Supplements
- The Complete Guide to Probiotic Strains
- The Scoop About Your Poop: What Your Bowel Habits Say About You
- Natural Relief for Constipation
- Natural Relief for Diarrhea
- Choosing the Right Gut Health Lab Test for You
- Natural Relief for Reflux
- Natural Relief for Bloating and Gas
- Your Complete Guide to Prebiotics
- Your Complete Guide to Digestive Enzymes
- Natural Alternatives to Antibiotics
- Natural Solutions for Candida
- Holistic Solutions for SIBO
- Holistic Support for Gut Inflammation
- Holistic Solutions for Histamine Intolerance
- Top Supplements for Microbiome Balance
- Bitters for Better Digestion
- Top Foods for Healthy Mucous Membranes
- Natural Support for the Migrating Motor Complex (MMC)
- Nutrient Content Tables for Plant-Based Eating
- The Complete Guide to Eliminating Parasites Naturally
Value: $197
Your Price: FREE
BONUS #7
The Good Gut Kitchen with Dr. Ritamarie
Meals packed with ingredients to overcome gut symptoms (with demos & recipes)

We have the lovely Dr. Ritamarie Loscalzo at the helm of The Good Gut Kitchen cooking demos and recipes. Dr. Ritamarie is a Functional Medicine and Nutrition Expert, and founder of the Institute of Nutritional Endocrinology. She’s also a licensed Doctor of Chiropractic and a Diplomat of the American Clinical Nutrition Board.
With her cooking program, she’ll show you the exact recipes she used to help her clients overcome their gut symptoms and transform their health.
Start the day right with an Energizing Elixir, rejuvenate your body with a Seaweed Mushroom Salad, or enjoy a guilt-free Gut-Loving Pizza! You’ll also find a recipe book so you can follow at your own pace.
Value: $197
Your Price: FREE
BONUS #8
Microbiome Makeover with Chef Camila Skaf
Delicious gut-healing recipes & video tutorials for the whole family to enjoy

The best way to make sustainable change in your health journey is to make it enjoyable!
And that’s what we aim to do with The Microbiome Makeover led by plant-based Chef Camila Skaf. Chef Camila is a mainstay coach in our Goodness Lover community. In her cooking program, she will show you 16 easy-to-follow recipes with ingredients that were specifically chosen to nourish your gut bugs and restore balance in your microbiome.
Got a picky eater in the family? No problem! You’ll find recipes ranging from savory waffles, to tofu “meatballs”, to apricot vanilla parfait, and more. You’ll even see a brownie recipe to satisfy your sweet cravings!
Value: $197
Your Price: FREE
BONUS #9
28-Day Gut Restore Meal Plan
Plan your gut-healing meals for a whole month

Thinking of what to eat for the day can get stressful. How much more stressful would it be if you need to limit yourself to certain ingredients while your gut heals? Or how about adding more gut-friendly dishes that you’ve never tried before? Will you be able to add variety to your meals and not get bored with the same food over and over?
With our 28-Day Gut Restore Meal Plan, you can now easily eat your way to a happier gut.
You’ll enjoy a 4-week lineup of meal planning done for you—filled with breakfast, lunch, and dinner options you’ll actually enjoy eating.
Even if you don’t consider yourself a good cook, you’ll be able to create tasty gut-repairing foods for you and your whole family.
Plus, you’ll be handed weekly shopping lists so you’ll never be without a key ingredient – saving you time and money on your road to restoration.
Value: $247
Your Price: FREE
BONUS #10
Step-by-Step Guide to Total Body Detoxification
Discover how to remove toxin buildup in your body — safely

Toxins are some of the biggest enemies of our gut.
Unfortunately, we’re surrounded by toxic sources all around us – including our foods, our clothes, even the air we breathe. While it’s tempting to detox straight away, you might do more harm than good if you don’t know how to do it right.
This video masterclass and comprehensive guidebook will help you detox safely and gently, without jumping into harsh protocols that might do more harm than good.
Value: $197
Your Price: FREE
BONUS #11
The Goodness Lover Wellness Journal
Your accountability partner and journal

Our Platinum Premium Package also comes with our brand-new The Goodness Lover Wellness Journal. Think of this as your little accountability partner.
Every day for the next six weeks, we’ll ask a few questions about your health to keep you on track. What did you eat today? How would you rate your mood? What did you struggle with today?
You can answer these questions on the PDFs you’ll receive or print this journal and do the handwritten route. This will help you plan ahead, stay motivated, and keep your goals in mind.
Over time, you’ll be able to see how far you’ve gone. And when you feel like you’re not progressing at all or your progress is moving at a very slow pace, all you need to do is look through your journal and see how much you’ve changed since Day 1!
Value: $47
Your Price: FREE
BONUS #12
Goodness Lover Team Coaching
Get personalized support on your healing journey

In October of 2022, the prestigious journal Frontiers in Public Health released conclusive evidence that coaching programs make a significant and measurable difference in helping people reach their health goals.
What’s even more interesting is that the data reveals that one of the most important aspects of an effective life-changing health coaching program is emotional support. In order to be sure you have all of the information and support you need to succeed, we are offering you access to our Goodness Lover Inner Circle Group for 6 months.
This is where you can…
- Connect with your coaching team of nutritionists and naturopaths
- Get bonus recipe suggestions and meal prep hacks
- Participate in mini challenges to reinforce your progress
- Meet other people who share your values and care about your success
- Participate in regular check-ins to keep you on track
- Ask questions and get extra help when you need it
Value: $497
Your Price: FREE
BONUS #13
Certificate of Completion
Test your gut knowledge & celebrate your achievements

Get ready to feel accomplished, educated, and yes, a little wiser!
Once you finish the Microbiome program, you’ll be invited to take a course assessment to confirm how much new knowledge you’ve acquired.
When you pass, you’ll be awarded a Certificate of Completion for all your hard work. Download it, print it, display it in your office, or post it on social media – it’s entirely up to you.
You’ve put in the effort… now it’s time to celebrate your achievements!
Value: $57
Your Price: FREE
BONUS #14
Expert Directory
Connect with gut experts worldwide

Want to connect directly with the educators in series? You’ll find the full roster and bios of the experts from the Microbiome masterclass inside The Expert Guide.
“Meet” the doctors, scientists, researchers, and nutritionists featured in the 10-part docuseries, as well as contact information for each of them so you can connect in the real world.
Value: $14
Your Price: FREE


You're Protected By Our 30-Day Guarantee
When you’re buying clothes, you can try them on. When you’re buying a car, you can test drive it. We believe you should have the same peace of mind with your health investments too. So, we’re giving you up to 30 days to try The Microbiome program, dive into our resources, and experience the difference it makes when you are able to address microbiome dysfunction at its root.
If you’re not over-the-moon thrilled with your experience, simply send us an email to start the refund process. It’s that simple!
Daniel Wiedemann
Customer Support Manager
Please Choose Your Platinum Package Today and Take Advantage of the Discounts, Available For a Short Time.
BONUS OFFER FOR A LIMITED TIME!
PLATINUM DIGITAL
ONLINE ACCESS

$2702
$197
- 10 Episodes Videos (Online Access)
- 10 Episode Transcripts (PDF Download)
- 10 Episode Audios (MP3 Downloads)
- BRAND NEW BONUS: Our 4-week Implementation Guide (PDF Download)
($147 value - YOURS FREE!)
- BONUS: Full-Length Interviews + Transcripts (Online Access & PDF Download)
($197 value - YOURS FREE!)
- BONUS: Expert Q&A Sessions Library with Over 50+ Videos! (Online Access)
($147 value - YOURS FREE!)
- BONUS: Episode Summaries and Protocols (PDF Download)
($297 value - YOURS FREE!)
- BONUS: Quick-Start Gut Breakthrough Guides (PDF Download)
($197 value - YOURS FREE!)
- BONUS: The Good Gut Kitchen with Dr. Ritamarie (Recipes + Cooking Demonstrations) (Online Access & PDF Download)
($197 value - YOURS FREE!)
- BONUS: The Microbiome Makeover: Gut-Healing Recipes & Tutorials with Chef Camila Skaf (Online Access & PDF Download)
($197 value - YOURS FREE!)
- BONUS: 28-Day Gut Restore Meal Plan + Shopping Lists (PDF Download)
($247 value - YOURS FREE!)
- BONUS: The Step-By-Step Guide to Total Body Detoxification (PDF Download)
($197 value - YOURS FREE!)
- BONUS: The Goodness Lover Wellness Journal (PDF Download)
($47 value - YOURS FREE!)
- BONUS: The Goodness Lover Inner Circle Community (Online Access)
($497 value - YOURS FREE!)
- BONUS: Certificate of Completion (PDF Download)
($57 value - YOURS FREE!)
- BONUS: Expert Directory (PDF Download)
($14 value - YOURS FREE!)

(Price Quoted in USD)
BONUS OFFER FOR A LIMITED TIME!
Best Value!
PLATINUM PREMIUM
DIGITAL & SHIPPED PRODUCT

$3300.85

$279
- 10 Episodes Videos (DVDs & Online Access)
- 10 Episode Transcripts (Bound Book & PDF Download)
- 10 Episode MP3 Audios (MP3 Downloads)
- BONUS: Gut Restore Supplement Package (Shipped)
($154.85 value - YOURS FREE!) Includes:

-
Better Gut Prebiotic Fiber Plus (
$59.95Value, Yours FREE!) -
Digest & Debloat Pro (
$49.95Value, Yours FREE!) -
L-Glutamine Powder (
$44.95Value, Yours FREE!)
- BRAND NEW BONUS: Our 4-week Implementation Guide (PDF Download)
($147 value - YOURS FREE!)
- BONUS: Full-Length Interviews + Transcripts (Online Access & PDF Download)
($197 value - YOURS FREE!)
- BONUS: Expert Q&A Sessions Library with Over 50+ Videos! (Online Access)
($147 value - YOURS FREE!)
- BONUS: Episode Summaries and Protocols (PDF Download)
($297 value - YOURS FREE!)
- BONUS: Quick-Start Gut Breakthrough Guides (PDF Download)
($197 value - YOURS FREE!)
- BONUS: The Good Gut Kitchen with Dr. Ritamarie (Recipes + Cooking Demonstrations) (Online Access & PDF Download)
($197 value - YOURS FREE!)
- BONUS: The Microbiome Makeover: Gut-Healing Recipes & Tutorials with Chef Camila Skaf (Online Access & PDF Download)
($197 value - YOURS FREE!)
- BONUS: 28-Day Gut Restore Meal Plan + Shopping Lists (PDF Download)
($247 value - YOURS FREE!)
- BONUS: The Step-By-Step Guide to Total Body Detoxification (PDF Download)
($197 value - YOURS FREE!)
- BONUS: The Goodness Lover Wellness Journal (PDF Download)
($47 value - YOURS FREE!)
- BONUS: The Goodness Lover Inner Circle Community (Online Access)
($497 value - YOURS FREE!)
- BONUS: Certificate of Completion (PDF Download)
($57 value - YOURS FREE!)
- BONUS: Expert Directory (PDF Download)
($14 value - YOURS FREE!)

(Price Quoted in USD)
*All digital products are available instantly after purchase. Your physical items will ship within 5-10 business days.
BONUS OFFER FOR A LIMITED TIME!
PLATINUM PHYSICAL
SHIPPED PRODUCT

$2999
$279
- 10 Episodes Videos (DVDs)
- 10 Episode Transcripts (Bound Book)
- 10 Episode MP3 Audios
- BRAND NEW BONUS: Our 4-week Implementation Guide (PDF Download)
($147 value - YOURS FREE!)
- BONUS: Full-Length Interviews + Transcripts (Online Access & PDF Download)
($197 value - YOURS FREE!)
- BONUS: Expert Q&A Sessions Library with Over 50+ Videos! (Online Access)
($147 value - YOURS FREE!)
- BONUS: Episode Summaries and Protocols (PDF Download)
($297 value - YOURS FREE!)
- BONUS: Quick-Start Gut Breakthrough Guides (PDF Download)
($197 value - YOURS FREE!)
- BONUS: The Good Gut Kitchen with Dr. Ritamarie (Recipes + Cooking Demonstrations) (Online Access & PDF Download)
($197 value - YOURS FREE!)
- BONUS: The Microbiome Makeover: Gut-Healing Recipes & Tutorials with Chef Camila Skaf (Online Access & PDF Download)
($197 value - YOURS FREE!)
- BONUS: 28-Day Gut Restore Meal Plan + Shopping Lists (PDF Download)
($247 value - YOURS FREE!)
- BONUS: The Step-By-Step Guide to Total Body Detoxification (PDF Download)
($197 value - YOURS FREE!)
- BONUS: The Goodness Lover Wellness Journal (PDF Download)
($47 value - YOURS FREE!)
- BONUS: The Goodness Lover Inner Circle Community (Online Access)
($497 value - YOURS FREE!)
- BONUS: Certificate of Completion (PDF Download)
($57 value - YOURS FREE!)
- BONUS: Expert Directory (PDF Download)
($14 value - YOURS FREE!)

(Price Quoted in USD)
*All digital products are available instantly after purchase. Your physical items will ship within 5-10 business days.

At Goodness Lover, we believe that a healthy gut is the foundation for a vibrant and energized life. As such, we're committed to providing actionable, research-driven, and engaging educational courses that empower you to unlock the power of your gut microbiome and achieve your healthiest self. We're proud to collaborate with world-renowned doctors and educators to deliver accurate, up-to-date, and reliable information to guide you on your wellness journey. To date, over 1.4 million people have engaged with our live educational events.
Join Us In Creating A Health Revolution


Sarah Otto, M. Human Nutrition
Nutritionist & Co-Founder of Goodness Lover
I am someone who once thought that my sore joints that made me limp around my house, my crippling fatigue I felt after each meal I ate, my anxiety, and my dark and deeply sad moments, were all just my lot in life.
And like many, I spent years caught in a cycle of hope and disappointment. I tried countless supplements, diets, and treatments, each promising to be the magic bullet that would finally restore my health. I consulted with doctors and read countless blogs by “health gurus”, hoping that someone would have the answer.
Each new solution brought a glimmer of hope, but it always faded away as my symptoms persisted. I felt like a guinea pig in an endless experiment, constantly testing new products and strategies, only to be left feeling worse than before.
The worst part? I was pouring my hard-earned money into these solutions, but none of them seemed to work. It was like throwing money into a bottomless pit, with no end in sight.
I was tired, frustrated, and on the verge of giving up. I couldn’t help but wonder, ‘Is there a better way?'”
Just when I was about to lose hope, I stumbled upon some information that changed everything. It wasn’t another supplement or a newfangled treatment. It wasn’t a short-term “fix” or a magic pill. It was something entirely different.
I discovered a new approach to health that went beyond treating symptoms. This new approach targeted the root cause of my issues, focusing on restoring balance and harmony at the core of my body.
This approach was different from anything I had tried before. It didn’t involve gulping down handfuls of supplements every day or following a restrictive diet. Instead, it was about understanding my body’s unique needs and providing it with the right nourishment and care.
And honestly, this newfound approach changed my life.
Fast forward to today (and a master’s degree in nutrition, seven docu-series, and millions of video views later), I now dedicate my days to doing my best to help others understand this crucial information. My little team and I take great pride in creating the content, the tools, and the warm and vibrant community individuals need to succeed on their health journey.
I don’t want anyone to have to stumble around looking for this information like I did. I don’t want anyone to be unnecessarily sick just because they didn’t have the right information. And it’s my hope that this special package we’ve put together will be the life-changing natural solution you’ve been looking for.

